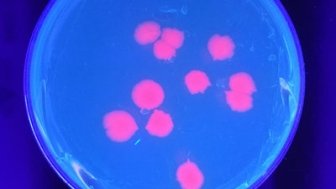
Biohackers Aim To Make Homebrew Insulin, But Don't Try It Yet

In the News
<h1 class="program-skin--color">In the News</h1><p>Within major news outlets, magazines, and academic journals, journalists and experts analyze a range of “citizen health innovators” profiles, unveiling their stories and illustrating the social, policy and ethical challenges behind patient empowerment.</p>
Explore more related to this collection
30
results